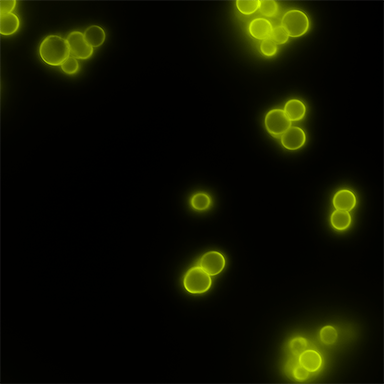
Microcapsules formulated from immune signals, immune polyelectrolyte multilayer capsules (iPEMs). From an immunoengineering study on designing therapeutics for autoimmune disease in multiple sclerosis.
Copyright © 2025 Robert "Smitty" Oakes, PhD

Transforming treatment efficacy, patient quality-of-life, and therapeutic accessibility.
The Oakes Research Laboratory leverages nanoscale biomolecular self-assembly and microfabrication to engineer immunotherapies and drug delivery systems that target innate immunity to regulate autoimmunity and cancer metastasis.

Lab Mission Statement
The mission of the Oakes Research Laboratory is to pursue transformative research and training for career and personal growth. As outlined in our Research description, we work in immunoengineering with a focus on how innate immune cells integrate cues from biomolecules and biomaterial delivery systems during disease. Our work integrates nanotechnology, microfabrication, and biomaterial approaches with immunology, gene expression regulation, single-cell and spatial transcriptomics to develop immunotherapies, drug delivery systems, and diagnostics. This approach to precision engineering and medicine can improve both the efficacy and accessibility of treatments for autoimmunity and cancer. Our core Values include innovation and translation, experimental rigor and responsibility, integration of diverse perspectives and tools, inclusion and belonging, enabling opportunities at multiple career stages, and maintaining a team-oriented philosophy. We implement these values in the laboratory and beyond through outreach initiatives. Every day, we focus on how we can innovate healthcare solutions that improve folks’ quality of life or give them more time with loved ones. – The Team
Recent Oakes Lab News
A collection of recent updates about our team and ongoing research at the University of Delaware.











